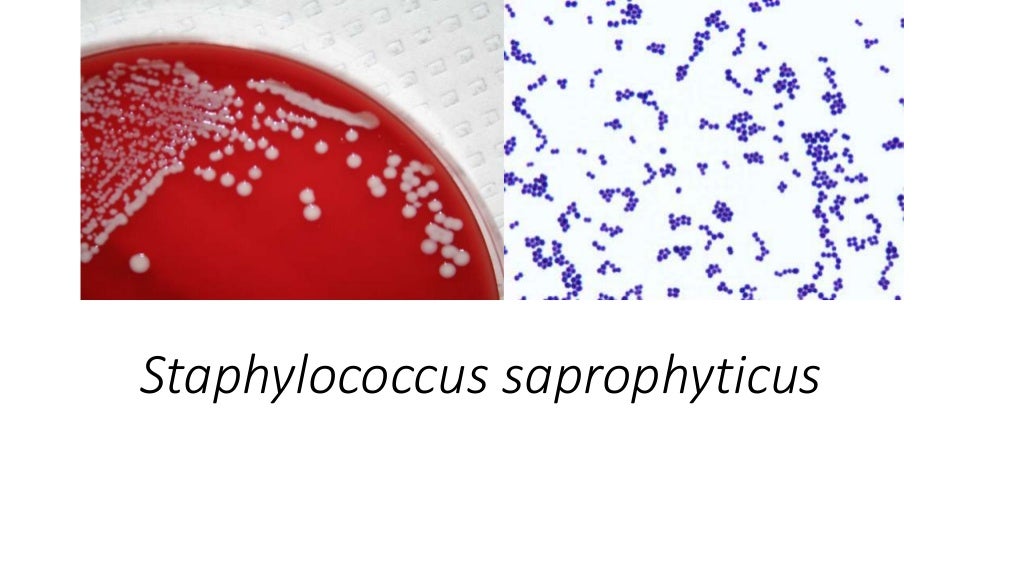
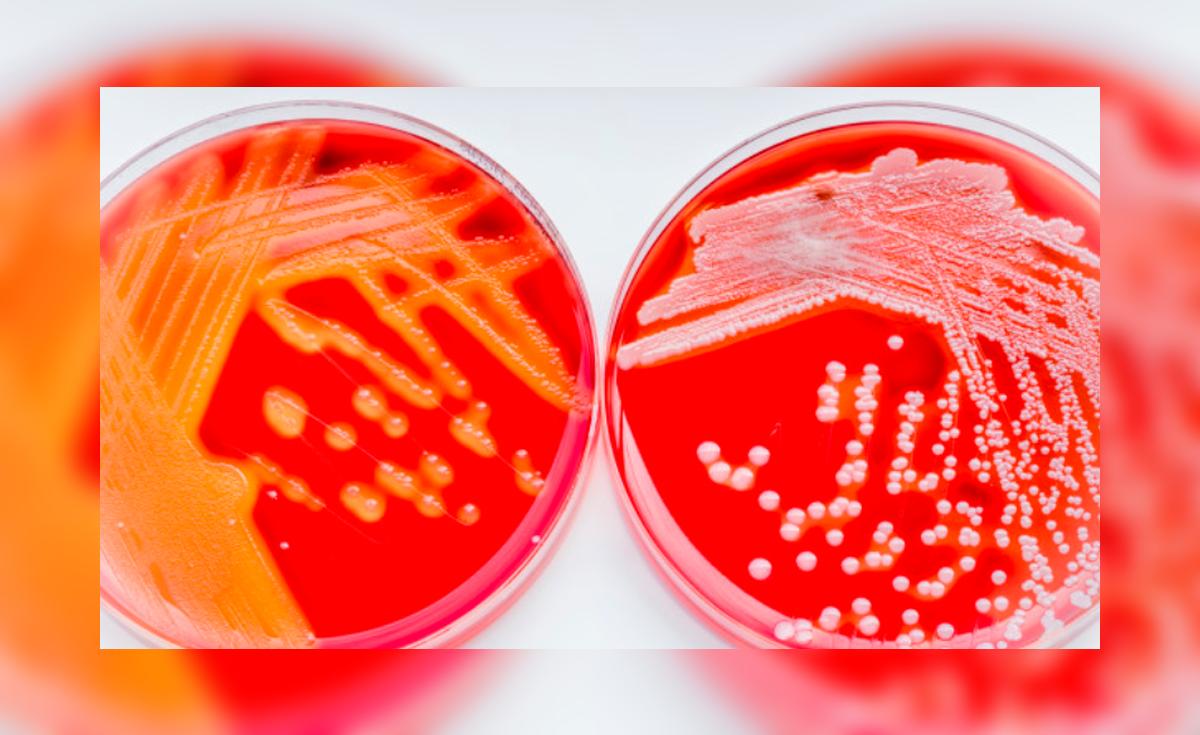

Staphylococcus haemolyticus кое
Staphylococcus haemolyticus кое 112 фотографий
Опель корса торпеда
Сайт крымское сельское поселение
В течение недели вдоль речки робкий луч
Желейный медведь валера в майнкрафте
Билеты пдд 2025 решать с изменениями
Кличка для собаки мальчика на букву м
Самый чистый воздух на земле
Belly scene
Красный десептикон
Памятный словарь
Кабачковая икра на кг кабачков
Можно ли ребенку смесь при температуре
Атом 32 браузер
Какой аккумулятор на мопеде альфа 110
U scribe jig
Сталь эмаль производитель
Dark but just a game
Время намаза в балашихе ханафи мазхаб 2025
Приключения космического века
Как пить валериану экстракт